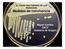
EL FUEGO BACTERIANO DE LAS ROSÁCEAS Medidas de convivencia. Miguel Cambra CSCV Gobierno de Aragón

Frutales Cepellón
|
|
|
- María Victoria Olivera Ramos
- hace 7 años
- Vistas:
Transcripción
1
2 Frutales Cepellón
3 ALBARICOQUERO (Prunus armeniaca) BULIDA ALBARICOQUERO (Prunus armeniaca) CORBATÓ ALBARICOQUERO (Prunus armeniaca) MONIQUÍ ALMENDRO (Prunus dulcis) GUARA Naranja FCPA FMUA FMDA FMTA / naranja FCPA FMDA FMTA0020 Julio za media Muy bueno FCPA FMUA FMDA FMTA0030 -Octubre Semi-mollar, firme y dura FCPA FMUA FMDA FMTA0040 AVELLANO (Corylus avellana) NEGRETA DE TARRAGONA CEREZO (Prunus avium) NAPOLEÓN CEREZO (Prunus avium) SUMMIT CEREZO (Prunus avium) BURLAT CÁSCARA: Dura Intenso 1,5-3 m Mayo- Lisa y fina Rosa Jugoso y agradable za dura Rojo claro Afresado Mayo y lisa Dura y color púrpura vinoso Agradable FCPA FMTA0050 FCPA FMUA FMDA FMTA0070 FCPA FMDA FMTA0075 FCPA FMUA FMDA FMTA0080 CEREZO (Prunus avium) PICOTA CEREZO (Prunus avium) GUINDO CIRUELO (Prunus domestica) SANTA ROSA CIRUELO (Prunus domestica) GOLDEN JAPAN -Julio Muy firme y crujiente Exquisito FCPA FMUA FMDA FMTA0090 za media Púrpura Exquisito FCPA FMDA FMTA0100 Julio Medianamente firme Amarilla rosada y jugosa FCPA FMUA FMDA FMTA0110 Julio Lisa Amarilla Jugoso y agradable FCPA FMUA FMDA FMTA0120 CIRUELO (Prunus domestica) STANLEY CIRUELO (Prunus domestica) REINA CLAUDIA VERDE CIRUELO (Prunus domestica) FRIAR GRANADO (Punica granatum) MOLLAR DE ELCHE Verde amarillento Azucarado FCPA FMDA y lisa Amarilla Muy azucarado 2-4 m FCPA FMUA FMDA FMTA0130 Bastante firme Fuerte, jugosa amarillo-ambar FCPA FMDA FMTA0140 Octubre-Noviembre Dura media De grano grueso y pepita muy reducida Acidulado 2-4 m FCPA FMDA FMTA0150
4 Frutales HIGUERA (Ficus carica) NAPOLITANA HIGUERA (Ficus carica) BLANCA GOTA DE MIEL KAKI (Diospyros kaki) ROJO BRILLANTE KAKI (Diospyros kaki) SHARON Blanco rosáceo Muy dulce FCPA FMUA FMDA FMTA0152 -Octubre Excelente 2-4 m FCPA FMUA FMDA FMTA0155 Octubre Firma Anaranjada FCPA FMDA FMTA0160 Octubre Anaranjada 2-3 m FCPA KIWI (Actinidia chinensis) JENNY (autofértil) BELLEZA DE ROMA GOLDEN DELICIOUS STARKING DELICIOUS Verde FRUTO: Alargado ÁRBOL: Vigoroso 2-3 m FMDA Amarillo-rojo FCPA FMDA FMTA0170 Lisa Amarillenta Jugoso FCPA FMUA FMDA FMTA0180 -Octubre Amarillenta Exquisito 2-4 m FCPA FMUA FMDA FMTA0190 VERDE DONCELLA REINETA BLANCA DEL CANADÁ REINA DE REINETAS FUJI -Octubre Tersa Jugosa perfumada FCPA FMDA FMTA Áspera Semi-firme Acidulado, azucarado y perfumado 2-4 m FCPA FMUA FMDA FMTA Agradable FCPA FMDA FMTA0200 Tersa Anaranjada -ácido FCPA FMUA FMDA FMTA0210 GRANNY SMITH REINETA GRIS (Tabardilla) ROYAL GALA MELOCOTONERO (Prunus persica) AMARILLO DE AGOSTO Octubre Tersa Acidulado dulce FCPA FMDA Áspera Semi firme Acidulado FCPA FMDA FMTA Crujiente Jugoso azucarado FCPA FMDA FMTA0215 Amarilla, muy consistente, jugosa y perfumada Azucarado FCPA FMUA FMDA FMTA0220
5 MELOCOTONERO (Prunus persica) ALEJANDRO DUMAS MELOCOTONERO (Prunus persica) SUDANELL MELOCOTONERO (Prunus persica) PARAGUAYO MEMBRILLERO (Cydonia oblonga) GIGANTE DE WRANJA Amarilla y dura FCPA FMUA FMDA FMTA0230 Julio Amarilla y jugosa FCPA FMDA FMTA0240 Julio- con estrías rojas Muy azucarado FCPA FMDA FMTA0250 Noviembre Amarilla Ácido azucarado FCPA FMDA FMTA0260 NASHI (Pyrus asiatica) SHINSEIKI NECTARINA (Prunus nucipersica) FANTASÍA NECTARINA (Prunus nucipersica) SNOW QUEEN NÍSPERO (Eriobotrya japonica) ARGELINO Dura y crujiente FCPA FMTA0270 CÁSCARA: Consistente Amarilla con rojo, fibrosa Acidulado FCPA FMUA FMDA FMTA0280 Consistente Acidulado FCPA FMDA FMTA0290 FRUTO: Grueso ÁRBOL: Vigor medio Anaranjada FMTA0300 NOGAL (Juglans regia) OLIVO (Olea europaea) MANZANILLA PARRA (Vitis vinifera) MOSCATEL ROMANO PARRA (Vitis vinifera) ROSSETI Octubre Dura 3-6 m FCPA Octubre No adherente Verde - Morado Agradable FCPA FMUA FMDA Dura Muy dulce 2-3 m Bolsa FRPR FMUA FMDA FMTA Gruesa Carnosa 2-3 m Bolsa FRPR FMUA2307 PARRA (Vitis vinifera) CARDINAL BLANQUILLA DE ARANJUEZ ERCOLINI CASTELL Dura 2-3 m Bolsa FRPR FMUA FMDA FMTA FCPA FMUA FMDA FMTA0340 Julio Blanco crema FCPA FMUA FMDA FMTA0350 Bastante fuerte, crujiente y granulosa Azucarado 3-4 m FCPA FMDA FMTA0360
6 Frutales CONFERENCE RED BARTLET WILLIAMS CEREZO (Prunus avium) - Bastante firme Fino FCPA FMUA FMDA FMTA0370 Tersa Blanco verdoso FCPA FMDA FMTA0380 Tersa consistente Muy dulce FCPA FMDA FMTA0390 y lisa rojo claro y jugoso FCEN FMDA CIRUELO (Prunus domstica) MELOCOTONERO (Prunus persica) NECTARINA (Prunus nucipersica) y lisa Amarilla Muy azucarado Lisa Amarillenta Jugoso Amarilla y dura Consistente Amarilla con rojo, fibrosa Acidulado FCEN FMDA FCEN FMDA FCEN FMDA FCEN FMDA LIMONERO (Citrus limon) MANDARINO (Citrus reticulata) NARANJO (Citrus sinensis) - FCEN FMDA Mayo- y lisa Amarilla, muy jugosa Ácido FCPC Fácil de romper Anaranjada, jugosa 2-4 m FCPC Diciembre Lisa Naranja Jugoso y agradable FCPC POMELO (Citrus paradisia) REDBLUSH KIWI (Actinidia chinensis) -Octubre Amarillo anaranjado Tersa Acidulado FCPC Vellosa y jugosa Poco ácido 2-3 m FCPK
7
8
9
10
11
12
Frutales preplantados 2
 Frutales preplantados 2 Frutales de 2 años en cepellón (1,5 m aprox.) REF.: FCPA 0525 REF.: FCPA 0530 REF.: FCPA 0510 REF.: FCPA 0520 REF.: FCPA 0502 REF.: FCPA 0505 4 Frutales de 2 años en cepellón (1,5
Frutales preplantados 2 Frutales de 2 años en cepellón (1,5 m aprox.) REF.: FCPA 0525 REF.: FCPA 0530 REF.: FCPA 0510 REF.: FCPA 0520 REF.: FCPA 0502 REF.: FCPA 0505 4 Frutales de 2 años en cepellón (1,5
Membrillero. Variedad Wranja
 Membrillero Variedad Wranja Cydonia oblonga El Membrillero es un pequeño árbol de hoja caduca, que no suele superar los 5 metros de altura. Tiene la copa abierta y poco densa. En primavera, en las axilas
Membrillero Variedad Wranja Cydonia oblonga El Membrillero es un pequeño árbol de hoja caduca, que no suele superar los 5 metros de altura. Tiene la copa abierta y poco densa. En primavera, en las axilas
Árboles frutales en maceta para jardinería. Por la calidad, por el progreso, por un servicio pleno todo el año.
 Árboles frutales en maceta para jardinería Por la calidad, por el progreso, por un servicio pleno todo el año. Hernandorena. Somos una empresa con muchos años de experiencia en la producción y comercialización
Árboles frutales en maceta para jardinería Por la calidad, por el progreso, por un servicio pleno todo el año. Hernandorena. Somos una empresa con muchos años de experiencia en la producción y comercialización
OLEA CON FORMA NATURAL
 OLEA CON FORMA NATURAL ON01 OLEA EUROPAEA C25cm- 10L 6/8 120/140 ON02 ( Olivo común) C25cm- 10L 8/10 120/140 ON03 C 15L 10/12 120/140 ON33 C35L 12/14 120/140 ON34 C45L 14/16 120/140 ON06 C50L 16/18 140/160
OLEA CON FORMA NATURAL ON01 OLEA EUROPAEA C25cm- 10L 6/8 120/140 ON02 ( Olivo común) C25cm- 10L 8/10 120/140 ON03 C 15L 10/12 120/140 ON33 C35L 12/14 120/140 ON34 C45L 14/16 120/140 ON06 C50L 16/18 140/160
PROCEDIMIENTO Y TABLA DE DISTRIBUCION HIPERGEOMETRICA A UTILIZARSE EN EL MUESTREO PARA DETERMINAR EL PORCENTAJE DE INGESTACION PRE-TRATAMIENTO
 Anexo I NOMINA DE PRODUCTOS VEGETALES HOSPEDEROS DE: Ceratitis capitata - Anastrepha fraterculus: ACEROLA (Malpighia punicifolia L.) ARANDANO (Vaccinium corymbosum) BABACO (Carica pentagona) CARAMBOLA
Anexo I NOMINA DE PRODUCTOS VEGETALES HOSPEDEROS DE: Ceratitis capitata - Anastrepha fraterculus: ACEROLA (Malpighia punicifolia L.) ARANDANO (Vaccinium corymbosum) BABACO (Carica pentagona) CARAMBOLA
Tarifa
 2010-2011 Tarifa 2010-2011 Chiva I (Valencia) Chiva II (Valencia) Santa Amalia I (Badajoz) Santa Amalia II (Badajoz) Santa Amalia III (Badajoz) Ofi cinas y vivero central Ptda. Rosafi na, s/nº, Polig.
2010-2011 Tarifa 2010-2011 Chiva I (Valencia) Chiva II (Valencia) Santa Amalia I (Badajoz) Santa Amalia II (Badajoz) Santa Amalia III (Badajoz) Ofi cinas y vivero central Ptda. Rosafi na, s/nº, Polig.
Catálogo comercial. Sociedad Cooperativa Agraria San Sebastián.
 Catálogo comercial Catálogo comercial ÍNDICE Presentación...4-5 Calendarios de comercialización...6-7 Catálogo de Frutas...8-9 Situación Cereza...10-11 Albaricoque...12-13 LONDRES BERLÍN PARÍS ROMA ZARAGOZA
Catálogo comercial Catálogo comercial ÍNDICE Presentación...4-5 Calendarios de comercialización...6-7 Catálogo de Frutas...8-9 Situación Cereza...10-11 Albaricoque...12-13 LONDRES BERLÍN PARÍS ROMA ZARAGOZA
Capítulo 9 REGULACIONES USDA-APHIS
 Capítulo 9 REGULACIONES USDA-APHIS 9.1 Listado de Frutas de Chile, Registradas como Hospederos de Moscas de la Fruta y Autorizadas para Ingresar por todos los Puertos (Aéreos y Marítimos) a los Estados
Capítulo 9 REGULACIONES USDA-APHIS 9.1 Listado de Frutas de Chile, Registradas como Hospederos de Moscas de la Fruta y Autorizadas para Ingresar por todos los Puertos (Aéreos y Marítimos) a los Estados
BULLMANN EXPORTACIONES S.L es una empresa ubicada en el Norte de Alicante en la localidad de Pedreguer en la Comunidad Valenciana.
 BULLMANN EXPORTACIONES S.L es una empresa ubicada en el Norte de Alicante en la localidad de Pedreguer en la Comunidad Valenciana. BULLMANN EXPORTACIONES S.L pertenece a un grupo de empresas entre los
BULLMANN EXPORTACIONES S.L es una empresa ubicada en el Norte de Alicante en la localidad de Pedreguer en la Comunidad Valenciana. BULLMANN EXPORTACIONES S.L pertenece a un grupo de empresas entre los
Frutas FENIX IMPORTADAS QUE FRUTAS... VENDEMOS SALUD
 Frutas IMPORTADAS Manzanas Saludables Frutas IMPORTADAS La manzana es rica en vitaminas y minerales lo cual la convierte en una de las frutas más beneficiosas para la salud. Es el fruto ideal para comer
Frutas IMPORTADAS Manzanas Saludables Frutas IMPORTADAS La manzana es rica en vitaminas y minerales lo cual la convierte en una de las frutas más beneficiosas para la salud. Es el fruto ideal para comer
Catálogo comercial. Sociedad Cooperativa Agraria San Sebastián.
 Catálogo comercial Catálogo comercial ÍNDICE Presentación...4-5 Calendarios de comercialización...6-7 Catálogo de Frutas...8-9 Cereza...10-11 Situación Albaricoque...12-13 Ciruela...14-15 BILBAO Nectarina...16-17
Catálogo comercial Catálogo comercial ÍNDICE Presentación...4-5 Calendarios de comercialización...6-7 Catálogo de Frutas...8-9 Cereza...10-11 Situación Albaricoque...12-13 Ciruela...14-15 BILBAO Nectarina...16-17
VARIEDADES OFERTADAS EN LA CAMPAÑA DE FRUTALES
 VARIEDADES OFERTADAS EN LA CAMPAÑA DE FRUTALES 2014-15 DEL CABILDO DE GRAN CANARIA. CÍTRICOS CÍTRICOS ORNAMENTALES KUMQUAT, LIMENQUAT: Árboles de tamaño medio, fruto pequeño como una aceituna, de piel
VARIEDADES OFERTADAS EN LA CAMPAÑA DE FRUTALES 2014-15 DEL CABILDO DE GRAN CANARIA. CÍTRICOS CÍTRICOS ORNAMENTALES KUMQUAT, LIMENQUAT: Árboles de tamaño medio, fruto pequeño como una aceituna, de piel
CATÁLOGO DE VARIEDADES. Augusta. viveros
 CATÁLOGO DE VARIEDADES Índice La empresa...3 Artículos para Jardinería Frutal de 1, 2 y 3 años...4-5 Frutal enano, arbusto y dos especies...6-7 Rosales...8-9 Olivos y parras...10-11 Artículos para Agricultores
CATÁLOGO DE VARIEDADES Índice La empresa...3 Artículos para Jardinería Frutal de 1, 2 y 3 años...4-5 Frutal enano, arbusto y dos especies...6-7 Rosales...8-9 Olivos y parras...10-11 Artículos para Agricultores
Guía divulgativa para la identificación de árboles frutales de la Huerta de Lleida
 Guía divulgativa para la identificación de árboles frutales de la Huerta de Lleida Valero Urbina Vallejo Lleida, febrero de 2013 Índice Pag. Prólogo. 2 1. Peral. 3 2. Manzano.. 7 3. Melocotonero.. 10 4.
Guía divulgativa para la identificación de árboles frutales de la Huerta de Lleida Valero Urbina Vallejo Lleida, febrero de 2013 Índice Pag. Prólogo. 2 1. Peral. 3 2. Manzano.. 7 3. Melocotonero.. 10 4.
VARIEDADES OFERTADAS EN LA CAMPAÑA DE FRUTALES
 VARIEDADES OFERTADAS EN LA CAMPAÑA DE FRUTALES 2015-16 DEL CABILDO DE GRAN CANARIA. CÍTRICOS CÍTRICOS ORNAMENTALES KUMQUAT, LIMENQUAT: Árboles de tamaño medio, fruto pequeño como una aceituna, de piel
VARIEDADES OFERTADAS EN LA CAMPAÑA DE FRUTALES 2015-16 DEL CABILDO DE GRAN CANARIA. CÍTRICOS CÍTRICOS ORNAMENTALES KUMQUAT, LIMENQUAT: Árboles de tamaño medio, fruto pequeño como una aceituna, de piel
INTRODUCCIÓN MANZANAS. Características varietales
 INTRODUCCIÓN Durante el mes de agosto se realizó un monitoreo de la calidad de la oferta de manzanas y peras en el Mercado Modelo con el fin de informar su estado de situación en este momento del año.
INTRODUCCIÓN Durante el mes de agosto se realizó un monitoreo de la calidad de la oferta de manzanas y peras en el Mercado Modelo con el fin de informar su estado de situación en este momento del año.
Dossier Margalef-La Fruta de Palacio Folleto informativo
 Dossier Margalef-La Fruta de Palacio Folleto informativo Índice 01. la HISTORIA 02. las CIFRAS 03. la MARCA 04. la PRODUCCIÓN 05. el MAPA 06. el ÉXITO 07. el COMPROMISO 08. la CALIDAD 09. nuestros PRODUCTOS
Dossier Margalef-La Fruta de Palacio Folleto informativo Índice 01. la HISTORIA 02. las CIFRAS 03. la MARCA 04. la PRODUCCIÓN 05. el MAPA 06. el ÉXITO 07. el COMPROMISO 08. la CALIDAD 09. nuestros PRODUCTOS
LOS FRUTALES COMO ALTERNATIVA DE DESARROLLO PARA LA SIERRA
 LOS FRUTALES COMO ALTERNATIVA DE DESARROLLO PARA LA SIERRA La zona de la sierra apta para el cultivo de árboles frutales y donde se sustentan las posibilidades expuestas en esta charla, es la comprendida
LOS FRUTALES COMO ALTERNATIVA DE DESARROLLO PARA LA SIERRA La zona de la sierra apta para el cultivo de árboles frutales y donde se sustentan las posibilidades expuestas en esta charla, es la comprendida
CATÁLOGO DE PRODUCTOS FRESCOS VERDURAS
 CATÁLOGO DE PRODUCTOS FRESCOS VERDURAS LECHUGAS Batavia Hojas rizadas, verdes con extremos rojizos, de textura mantecosa. Cogollo suelto. Sabor algo ácido. En ensaladas, es mejor mezclarla con otras lechugas.
CATÁLOGO DE PRODUCTOS FRESCOS VERDURAS LECHUGAS Batavia Hojas rizadas, verdes con extremos rojizos, de textura mantecosa. Cogollo suelto. Sabor algo ácido. En ensaladas, es mejor mezclarla con otras lechugas.
Capítulo 1 Las especies frutales
 MORFOLOGÍA Y DESARROLLO VEGETATIVO DE LOS FRUTALES MONOGRAFÍAS DE FRUTICULTURA - N.º 5 PROYECCIÓN PARA CLASES Capítulo 1 Las especies frutales Prof. Valero Urbina Vallejo Actualización: 2010 1. EL CULTIVO
MORFOLOGÍA Y DESARROLLO VEGETATIVO DE LOS FRUTALES MONOGRAFÍAS DE FRUTICULTURA - N.º 5 PROYECCIÓN PARA CLASES Capítulo 1 Las especies frutales Prof. Valero Urbina Vallejo Actualización: 2010 1. EL CULTIVO
Modificación del Reglamento Técnico de Control y Certificación de plantas de vivero de frutales
 Modificación del Reglamento Técnico de Control y Certificación de plantas de vivero de frutales Jornada técnica organizada por la D.G. de la producción agrícola y ganadera de la Consejería de agricultura,
Modificación del Reglamento Técnico de Control y Certificación de plantas de vivero de frutales Jornada técnica organizada por la D.G. de la producción agrícola y ganadera de la Consejería de agricultura,
Dossier r Empresa Frutas cítri r cas La Rubia 2017
 Dossier Empresa Frutas cítricas La Rubia 2017 Índice 1. Frutas cítricos La Rubia... 3 2. Qué productos ofrece la empresa?... 4 2. 1 Limón... 5 2. 2 Naranja... 6 2. 3 Mandarina... 8 2. 4 Ciruela... 11 2.
Dossier Empresa Frutas cítricas La Rubia 2017 Índice 1. Frutas cítricos La Rubia... 3 2. Qué productos ofrece la empresa?... 4 2. 1 Limón... 5 2. 2 Naranja... 6 2. 3 Mandarina... 8 2. 4 Ciruela... 11 2.
METODOLOGIA DE RECOLECCION Y PROCESAMIENTO DE INFORMACION EN NOTICIAS DE MERCADO
 METODOLOGIA DE RECOLECCION Y PROCESAMIENTO DE INFORMACION EN NOTICIAS DE MERCADO Septiembre 2011 RECOLECCION Y PROCESAMIENTO DE DATOS A NIVEL DE MERCADOS FALTA UNA TABLA 1 B Formato N 2 72 PRODUCTOS 400
METODOLOGIA DE RECOLECCION Y PROCESAMIENTO DE INFORMACION EN NOTICIAS DE MERCADO Septiembre 2011 RECOLECCION Y PROCESAMIENTO DE DATOS A NIVEL DE MERCADOS FALTA UNA TABLA 1 B Formato N 2 72 PRODUCTOS 400
Seminario de Actualización Técnica en Frutales de Pepita
 Seminario de Actualización Técnica en Frutales de Pepita Variedades de manzano Jorge Soria, Julio Pisano, Danilo Cabrera, Maximiliano Dini, Pablo Rodríguez, Mariana Urraburu, Edgardo Disegna, Andrés Coniberti,
Seminario de Actualización Técnica en Frutales de Pepita Variedades de manzano Jorge Soria, Julio Pisano, Danilo Cabrera, Maximiliano Dini, Pablo Rodríguez, Mariana Urraburu, Edgardo Disegna, Andrés Coniberti,
22. Evolución de la producción agrícola según tipo de cultivo.
 2009 2010 2011 2012 2013 2014 TOTAL 2.956.754 2.944.700 3.004.273 2.985.087 3.349.606 3.412.074 CULTIVOS HERBÁCEOS 1.779.476 1.687.551 1.709.303 1.736.758 1.885.296 1.964.261 Cereales para grano 72.235
2009 2010 2011 2012 2013 2014 TOTAL 2.956.754 2.944.700 3.004.273 2.985.087 3.349.606 3.412.074 CULTIVOS HERBÁCEOS 1.779.476 1.687.551 1.709.303 1.736.758 1.885.296 1.964.261 Cereales para grano 72.235
Quiénes somos? También podemos gestionar la adquisición de variedades no producidas por nosotros. Consúltanos a este respecto.
 Viveros Gallardo Pasada Chivero s/n Varea 646 408 535 941 102 335 [email protected] 2014 Quiénes somos? Fundada en 2002, Viveros Gallardo es una empresa familiar dedicada a la selección, cultivo
Viveros Gallardo Pasada Chivero s/n Varea 646 408 535 941 102 335 [email protected] 2014 Quiénes somos? Fundada en 2002, Viveros Gallardo es una empresa familiar dedicada a la selección, cultivo
CATÁLOGO DE VARIEDADES TRADICIONALES DE FRUTALES
 CATÁLOGO DE VARIEDADES TRADICIONALES DE FRUTALES Invierno 2012-13 LAS VARIEDADES TRADICIONALES DE FRUTALES DE LAS SIERRAS DE BÉJAR Y FRANCIA Uno de los objetivos principales del Zahoz es la recuperación
CATÁLOGO DE VARIEDADES TRADICIONALES DE FRUTALES Invierno 2012-13 LAS VARIEDADES TRADICIONALES DE FRUTALES DE LAS SIERRAS DE BÉJAR Y FRANCIA Uno de los objetivos principales del Zahoz es la recuperación
Ministerio de Agroindustria Secretaría de Agregado de Valor
 BUENOS AIRES, VISTO el expediente N 1-0047-2110-004249-17-5 de la ADMINISTRACIÓN NACIONAL DE MEDICAMENTOS ALIMENTOS Y TECNOLOGÍA MÉDICA, ente descentralizado, dependiente del Ministerio de Salud; y CONSIDERANDO:
BUENOS AIRES, VISTO el expediente N 1-0047-2110-004249-17-5 de la ADMINISTRACIÓN NACIONAL DE MEDICAMENTOS ALIMENTOS Y TECNOLOGÍA MÉDICA, ente descentralizado, dependiente del Ministerio de Salud; y CONSIDERANDO:
M.AGUSTÍ Dr. Ingeniero Agrónomo Catedrático de Universidad Departamento de Producción Vegetal Universidad Politécnica. Valencia FRUTICULTURA
 M.AGUSTÍ Dr. Ingeniero Agrónomo Catedrático de Universidad Departamento de Producción Vegetal Universidad Politécnica. Valencia FRUTICULTURA Ediciones Mundi-Prensa Madrid Barcelona México 2010 INDICE Capítulo
M.AGUSTÍ Dr. Ingeniero Agrónomo Catedrático de Universidad Departamento de Producción Vegetal Universidad Politécnica. Valencia FRUTICULTURA Ediciones Mundi-Prensa Madrid Barcelona México 2010 INDICE Capítulo
MINISTERIO DE AGRICULTURA, PESCA Y ALIMENTACION
 JOSE MARIA AYALA DELGADO Agente de Extensión Agraria MINISTERIO DE AGRICULTURA, PESCA Y ALIMENTACION VARIEDADES DE CIRUELO El interés despertado últimamente por el cultivo del ciruelo hace aconsejable
JOSE MARIA AYALA DELGADO Agente de Extensión Agraria MINISTERIO DE AGRICULTURA, PESCA Y ALIMENTACION VARIEDADES DE CIRUELO El interés despertado últimamente por el cultivo del ciruelo hace aconsejable
OLEA EUROPAEA EL OLIVO "UNA DE NUESTRA ESPECIALIDAD"
 OLEA EUROPAEA EL OLIVO "UNA DE NUESTRA ESPECIALIDAD" ON01 OLEA EUROPAEA C25cm- 10L 6/8 120/140 ON02 ( Olivo) C25cm- 10L 8/10 120/140 ON33 C35L 12/14 120/140 ON34 C45L 14/16 120/140 ON06 C50L 16/18 140/160
OLEA EUROPAEA EL OLIVO "UNA DE NUESTRA ESPECIALIDAD" ON01 OLEA EUROPAEA C25cm- 10L 6/8 120/140 ON02 ( Olivo) C25cm- 10L 8/10 120/140 ON33 C35L 12/14 120/140 ON34 C45L 14/16 120/140 ON06 C50L 16/18 140/160
Boletín semanal de precios internacionales de frutas y hortalizas frescas en mercados mayoristas. N 23 Semana del 06 al 12 de junio
 Boletín semanal de precios internacionales de frutas y hortalizas frescas en mercados mayoristas N 23 Semana del 06 al 12 de junio Canadá Estados Unidos Francia Holanda Reino Unido TABLA DE CONTENIDO Placido
Boletín semanal de precios internacionales de frutas y hortalizas frescas en mercados mayoristas N 23 Semana del 06 al 12 de junio Canadá Estados Unidos Francia Holanda Reino Unido TABLA DE CONTENIDO Placido
ESPECIES Y VARIEDADES DE ÁRBOLES FRUTALES
 Agro Arga ESPECIES Y VARIEDADES DE ÁRBOLES FRUTALES ACEROLOS ITALIA MITAD SEPTIEMBRE AMARILLO GRANDE JULIETA MITAD SEPTIEMBRE ROJO GRANDE ALBARICOQUEROS AMAL MITAD JUNIO AMARILLO GRANDE BERGAROUGE 1º JULIO
Agro Arga ESPECIES Y VARIEDADES DE ÁRBOLES FRUTALES ACEROLOS ITALIA MITAD SEPTIEMBRE AMARILLO GRANDE JULIETA MITAD SEPTIEMBRE ROJO GRANDE ALBARICOQUEROS AMAL MITAD JUNIO AMARILLO GRANDE BERGAROUGE 1º JULIO
Calendario Verde 2016
 Calendario Verde PRODUCTOS DE TEMPORADA + SaludableS + SostenibleS + EconómicoS + SabrosoS Rodrigo de la Calle Chef creador de la GASTROBOTÁNICA, especialista en y y asesor en GASMA. Restaurante El Invernadero.
Calendario Verde PRODUCTOS DE TEMPORADA + SaludableS + SostenibleS + EconómicoS + SabrosoS Rodrigo de la Calle Chef creador de la GASTROBOTÁNICA, especialista en y y asesor en GASMA. Restaurante El Invernadero.
18. Evolución de la superficie de las tierras de cultivo según tipo de cultivo y sistema de cultivo, por municipios.
 - MURCIA (Región de) 2010 2011 2012 TOTAL 148.975 154.680 150.670 154.541 143.586 157.327 CULTIVOS HERBÁCEOS 45.641 58.219 48.339 59.231 44.804 61.946 Cereales para grano 43.141 6.355 45.675 6.491 42.057
- MURCIA (Región de) 2010 2011 2012 TOTAL 148.975 154.680 150.670 154.541 143.586 157.327 CULTIVOS HERBÁCEOS 45.641 58.219 48.339 59.231 44.804 61.946 Cereales para grano 43.141 6.355 45.675 6.491 42.057
M. AGUSTI Dr. Ingeniero Agrónomo Catedrático de Universidad Departamento de Producción Vegetal Universidad Politécnica. Valencia FRUTICULTURA
 M. AGUSTI Dr. Ingeniero Agrónomo Catedrático de Universidad Departamento de Producción Vegetal Universidad Politécnica. Valencia FRUTICULTURA Ediciones Mundi-Prensa Madrid Barcelona México 2004 INDICE
M. AGUSTI Dr. Ingeniero Agrónomo Catedrático de Universidad Departamento de Producción Vegetal Universidad Politécnica. Valencia FRUTICULTURA Ediciones Mundi-Prensa Madrid Barcelona México 2004 INDICE
Introducción. Variedades Europeas
 CIRUELA Marzo 2016 Introducción Según el MGAP, DIEA (2015) en la zafra 2013/2014 se produjeron aproximadamente 2.200 toneladas de ciruela. En dicha zafra se contabilizaron 422 productores, donde el 15%
CIRUELA Marzo 2016 Introducción Según el MGAP, DIEA (2015) en la zafra 2013/2014 se produjeron aproximadamente 2.200 toneladas de ciruela. En dicha zafra se contabilizaron 422 productores, donde el 15%
PLIEGO DE PRESCRIPCIONES TECNICAS CONCURSO FRUTAS Y VERDURAS 1) DEFINICION DEL OBJETO: ARTICULOS/CANTIDAD/PRECIO
 PLIEGO DE PRESCRIPCIONES TECNICAS CONCURSO 2008-0-26 FRUTAS Y VERDURAS 1) DEFINICION DEL OBJETO: ARTICULOS/CANTIDAD/PRECIO Nº Orden Código Nombre artículo Cantidad Precio ( ) Importe ( ) 1 030100 MANZANA
PLIEGO DE PRESCRIPCIONES TECNICAS CONCURSO 2008-0-26 FRUTAS Y VERDURAS 1) DEFINICION DEL OBJETO: ARTICULOS/CANTIDAD/PRECIO Nº Orden Código Nombre artículo Cantidad Precio ( ) Importe ( ) 1 030100 MANZANA
CATALOGO DE FRUTAS EXOTICAS
 CATALOGO DE FRUTAS EXOTICAS PHYSALIS (UCHUVA) Nombre Científico: Physalis peruviana L. Nombre Comercial: Physalis, Aguaymanto, Uchuva Origen: América del Sur. País Productor: Colombia Presentación: Uchuva
CATALOGO DE FRUTAS EXOTICAS PHYSALIS (UCHUVA) Nombre Científico: Physalis peruviana L. Nombre Comercial: Physalis, Aguaymanto, Uchuva Origen: América del Sur. País Productor: Colombia Presentación: Uchuva
LINEA: 325 - PLANTA VIVA CANARIAS MODULO: 2. TARIFA: 5.014 - MOD 2- VIVEROS DE VID Cep Madre de Patr.-CANARIAS PRODUCCION (UNIDADES)
 PLAN: 2.014 SECTOR PRODUCTIVO: 012 - Ornamental Página: 1 TARIFA: 5.014 - MOD 2- VIVEROS DE VID Cep Madre de Patr.-CANARIAS PRODUCCION (UNIDADES) CEPAS MADRES PA 1 ESTACA ESTAQUI TARIFA: 5.341 - MOD 2-
PLAN: 2.014 SECTOR PRODUCTIVO: 012 - Ornamental Página: 1 TARIFA: 5.014 - MOD 2- VIVEROS DE VID Cep Madre de Patr.-CANARIAS PRODUCCION (UNIDADES) CEPAS MADRES PA 1 ESTACA ESTAQUI TARIFA: 5.341 - MOD 2-
LINEA: 325 - PLANTA VIVA CANARIAS MODULO: 1. TARIFA: 5.018 - MOD 1- VIVEROS DE VID Cep Madre de Patr.-CANARIAS PRODUCCION (UNIDADES) CULTIVO VARIEDAD
 PLAN: 2.014 SECTOR PRODUCTIVO: 012 - Ornamental Página: 1 TARIFA: 5.018 - MOD 1- VIVEROS DE VID Cep Madre de Patr.-CANARIAS PRODUCCION (UNIDADES) CEPAS MADRES PA 1 ESTACA ESTAQUI TARIFA: 5.492 - MOD 1-
PLAN: 2.014 SECTOR PRODUCTIVO: 012 - Ornamental Página: 1 TARIFA: 5.018 - MOD 1- VIVEROS DE VID Cep Madre de Patr.-CANARIAS PRODUCCION (UNIDADES) CEPAS MADRES PA 1 ESTACA ESTAQUI TARIFA: 5.492 - MOD 1-
Aceituna sevillana Ajo. Aceitunas de azapa Ajo chileno. Bicarbonato Alcachofas. Canela entera Apio. Canela molida Arbejas. Comino entero Berenjenas
 V E R D U R A S F R U T A S F R U T O S S E C O S Y L E G U M B R E S O T R O S Acelga Arándanos Ajo seco Aceituna sevillana Ajo Cereza Almendra con cáscara Aceitunas de azapa Ajo chileno Chirimoya Almendra
V E R D U R A S F R U T A S F R U T O S S E C O S Y L E G U M B R E S O T R O S Acelga Arándanos Ajo seco Aceituna sevillana Ajo Cereza Almendra con cáscara Aceitunas de azapa Ajo chileno Chirimoya Almendra
los fruticultores saben que para que un Técnicas de aclareo en melocotón
 Técnicas de aclareo en melocotón ENRIQUE DÍAZ GÓMARA Y ÁLVARO BENITO CALVO los fruticultores saben que para que un árbol frutal pueda producir frutos de un tamaño y calidad aceptables y que, además, sea
Técnicas de aclareo en melocotón ENRIQUE DÍAZ GÓMARA Y ÁLVARO BENITO CALVO los fruticultores saben que para que un árbol frutal pueda producir frutos de un tamaño y calidad aceptables y que, además, sea
EL FUEGO BACTERIANO DE LAS ROSÁCEAS Medidas de convivencia. Miguel Cambra CSCV Gobierno de Aragón
EL FUEGO BACTERIANO DE LAS ROSÁCEAS Medidas de convivencia Miguel Cambra CSCV Gobierno de Aragón EL FUEGO BACTERIANO Erwinia amylovora -Descrita en 1780 -Primera enfermedad de plantas que se demostró estar
EL FUEGO BACTERIANO DE LAS ROSÁCEAS Medidas de convivencia Miguel Cambra CSCV Gobierno de Aragón EL FUEGO BACTERIANO Erwinia amylovora -Descrita en 1780 -Primera enfermedad de plantas que se demostró estar
Calendario Verde 2019
 Calendario Verde 0 Productos de Temporada más saludables, sostenibles, económicos y sabrosos Rodrigo de la Calle Propietario del Restaurante El Invernadero. Estrella Michelin. Asesor de y en Makro. Enero
Calendario Verde 0 Productos de Temporada más saludables, sostenibles, económicos y sabrosos Rodrigo de la Calle Propietario del Restaurante El Invernadero. Estrella Michelin. Asesor de y en Makro. Enero
Cátedra Botánica Taxonómica PLANTAS FRUTALES. Elaborado por: Ing. Agr. Lucas M. Carbone Biól. Marta E. Carreras
 Cátedra Botánica Taxonómica PLANTAS FRUTALES Elaborado por: Ing. Agr. Lucas M. Carbone Biól. Marta E. Carreras Basado en el original 2015 de la Dra. Elsa Fuentes Curso 2016 1 BIBLIOGRAFÍA RECOMENDADA Hill,
Cátedra Botánica Taxonómica PLANTAS FRUTALES Elaborado por: Ing. Agr. Lucas M. Carbone Biól. Marta E. Carreras Basado en el original 2015 de la Dra. Elsa Fuentes Curso 2016 1 BIBLIOGRAFÍA RECOMENDADA Hill,
